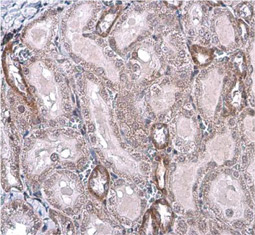

Cell markers are biochemical or genetic characteristics that distinguish and discriminate between different cell types. Although most are molecules expressed on the plasma membrane, cell markers are not limited to surface antigens and can include other components such as transcription factors. The unique composition and combination of cell markers allows researchers to accurately delineate the various cell types within a population. As the fields of regenerative medicine and molecular diagnostics continue to expand, the need to discover and describe novel cell-specific markers will become even more urgent.
GeneTex is proud to offer an outstanding selection of antibody reagents to facilitate your research, featuring antibodies against unique cell markers for detection of the various cell types highlighted below.